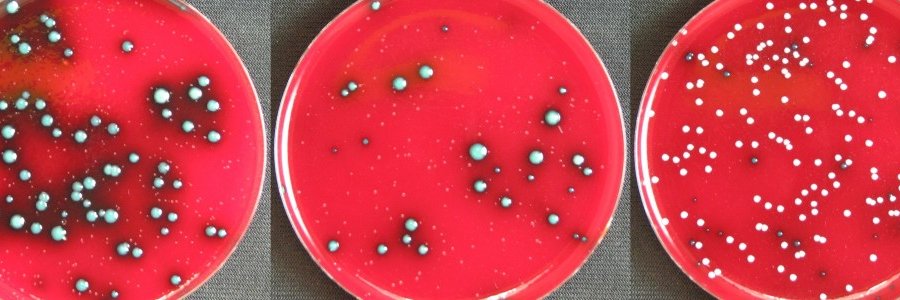
Devlin Lab banner

Check out our paper published today in @PNASNews! Gut microbiome–produced bile acid metabolite lengthens the circadian period in host intestinal cells | PNAS pnas.org/doi/10.1073/pn…
English
Devlin Lab
149 posts

@DevlinLab
A young lab at Harvard Medical School that uses chemical biology to study the human microbiome 🧪🔬🦠🧫 **student- & postdoc-run account**










Earlier this week we said ~see you later~ to one of the OG Devlin lab postdocs, Snehal Chaudhari, as she embarks on her journey as an Assistant Professor at @UWBiochem! We are so proud of her but we’ll miss her big time 😭













Join us for the ACS Chemical Biology Young Investigators Webinar on Tuesday Sept 13th! The event will feature 10 exciting speakers and takes place in two live sessions at 10 am EST and 8 pm EST. You can register and find more information here: go.acs.org/28s

